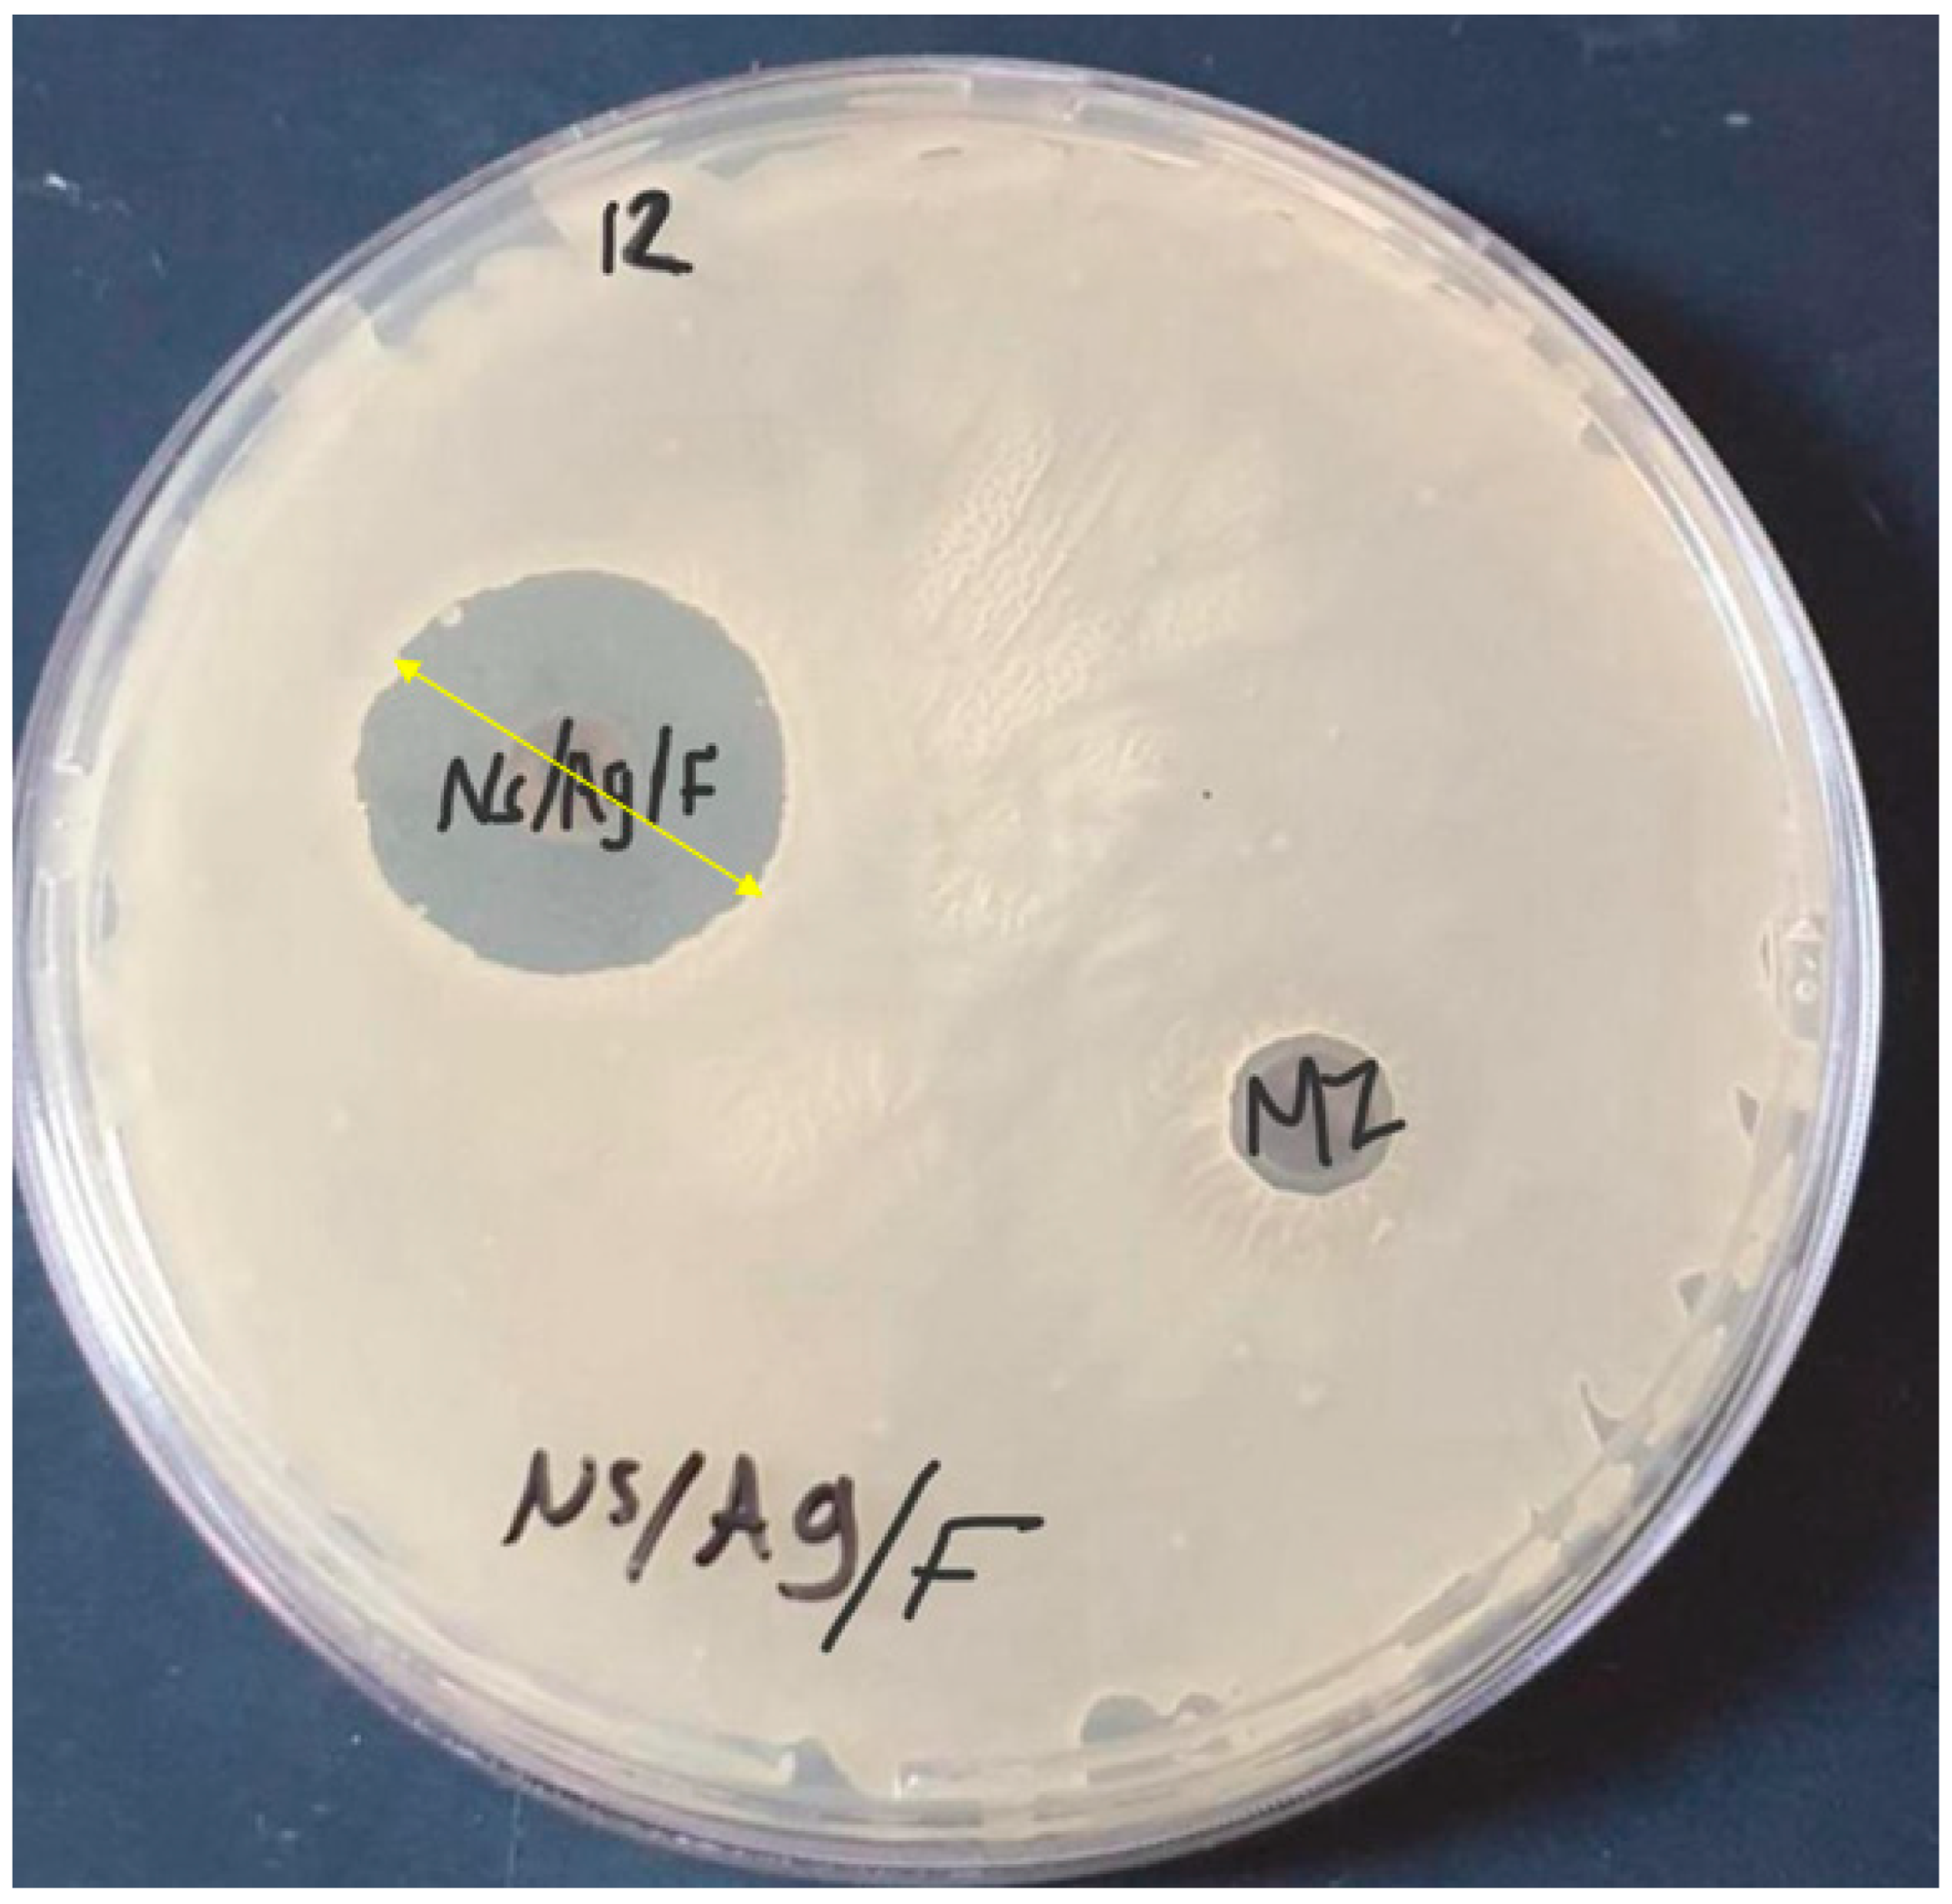
Microorganisms 12 00001 g006

Antibacterial Activities of Ag/Cellulose Nanocomposites Derived from Marine Environment Algae against Bacterial Tooth Decay
Abstract
:1. Introduction
2. Materials and Methods
2.1. Materials and Chemicals
2.2. Algae Collection
2.3. Extracting Cellulose from U. lactuca Green Alga
2.4. Synthesis of Nanocellulose
2.5. Silver Nanoparticle Preparation
2.6. Biosynthesis of Ag/Cellulose Nanocomposites
2.7. Mixing of Fluoride with Ag/Cellulose Nanocomposites
2.8. Characterization of Ag/Cellulose Nanocomposites
2.8.1. FTIR Spectroscopy Analysis
2.8.2. X-ray Diffraction (XRD)
2.8.3. Energy-Dispersive Spectroscopy (EDS)
2.8.4. Scanning Electron Microscopy (SEM)
2.8.5. Transmission Electron Microscopy (TEM)
2.9. Antibacterial Activity of Ag/Cellulose Nanocomposites/Fluoride against Bacteria Isolated from Dental Caries
2.9.1. Ethical Approval
2.9.2. Collection and Isolation of Bacterial Strains
2.9.3. Identification of Bacterial Isolates
2.9.4. Antimicrobial Susceptibility Tests
2.9.5. Antibacterial Activities of Cellulose, AgNPs, Nanocellulose, and Ag/Cellulose Nanocomposites with and without Fluoride against Isolated Bacteria
3. Results and Discussion
3.1. Characterization of Ag/Cellulose Nanocomposites
FTIR Spectroscopy Analysis
3.2. X-ray Diffraction (XRD) of Ag/Cellulose Nanocomposites
3.3. Energy-Dispersive Spectroscopy (EDS) of Ag/Cellulose Nanocomposites
3.4. Scanning Electron Microscopy (SEM) of Ag/Cellulose Nanocomposites
3.5. Transmission Electron Microscopy (TEM) of Ag/Cellulose Nanocomposites
- Leuconosticmesenteroides
3.6. Isolation and Identification of Bacterial Isolates on Mitis Salivarius (M-S) Agar
Isolation and Identification of Bacterial Isolates on De Man, Rogosa and Sharpe (MRS) Media
3.7. Antibiotic Susceptibility Pattern for Different Isolates
3.8. Antibacterial Activity of Cellulose, Nanocellulose, AgNPs, and Ag/Cellulose Nanocomposites with and without Fluoride against Antibiotic-Resistant Bacterial Isolates
4. Conclusions
Author Contributions
Funding
Data Availability Statement
Conflicts of Interest
References
- Thomas, P.; Duolikun, T.; Rumjit, N.P.; Moosavi, S.; Lai, C.W. Comprehensive review on nanocellulose: Recent developments, challenges and future prospects. J. Mech. Behav. Biomed. Mater. 2020, 110, 103884. [Google Scholar] [CrossRef] [PubMed]
- Hu, L.; Zheng, G.; Yao, J.; Liu, N.; Weil, B.; Eskilsson, M.; Karabulut, E.; Ruan, Z.; Fan, S.; Bloking, J.T. Transparent and conductive paper from nanocellulose fibers. Energy Environ. Sci. 2013, 6, 513–518. [Google Scholar] [CrossRef]
- Beck-Candanedo, S.; Roman, M.; Gray, D.G. Effect of Reaction Conditions on the Properties and Behavior of Wood Cellulose Nanocrystal Suspensions. Biomacromolecules 2005, 6, 1048–1054. [Google Scholar] [CrossRef] [PubMed]
- Wang, J.; Han, X.; Zhang, C.; Liu, K.; Duan, G. Source of Nanocellulose and Its Application in Nanocomposite Packaging Material: A Review. Nanomaterials 2022, 12, 3158. [Google Scholar] [CrossRef] [PubMed]
- Javed, P.R.; Zia, M.; Naz, S.; Aisida, S.O. Role of capping agents in the application of nanoparticles in biomedicine and environmental remediation: Recent trends and future. J. Nanobiotechnol. 2020, 18, 172. [Google Scholar] [CrossRef] [PubMed]
- Sokarya, R.; Abu El-Nagab, M.N.; Bekhit, M.; Atta, S. A potential antibiofilm, antimicrobial and anticancer activities of chitosan capped gold nanoparticles prepared by irradiation. Mater. Technol. 2021, 37, 493–502. [Google Scholar] [CrossRef]
- Morgan, X.C.; Huttenhower, C. Human microbiome analysis. PLoS Comput. Biol. 2012, 8, e1002808. [Google Scholar] [CrossRef]
- Mark Welch, J.L.; Rossetti, B.J.; Rieken, C.W.; Dewhirst, F.E.; Borisy, G.G. Biogeography of a human oral microbiome at the micron scale. Proc. Natl. Acad. Sci. USA 2016, 113, E791–E800. [Google Scholar] [CrossRef]
- Jia, G.; Zhi, A.; Lai, P.F.; Wang, G.; Xia, Y.; Xiong, Z.; Zhang, H.; Che, N.; Ai, L. The oral microbiota-a mechanistic role for systemic diseases. Br. Dent. J. 2018, 224, 447–455. [Google Scholar] [CrossRef]
- Uerlich, M.F.; Baker, S.R.; Day, P.F.; Brown, L.; Vettore, M.V. Common Determinants of Dental Caries and Obesity in Children: A Multi-Ethnic Nested Birth Cohort Study in the United Kingdom. Int. J. Environ. Res. Public Health 2021, 18, 12561. [Google Scholar] [CrossRef]
- Selwitz, R.H.; Ismail, A.I.; Pitts, N.B. Dental caries. Lancet 2007, 369, 51–59. [Google Scholar] [CrossRef] [PubMed]
- Rocha, G.R.; Sims, K.R., Jr.; Xiao, B.; Klein, M.I.; Benoit, D.S.W. Nanoparticle carrier codelivery of complementary antibiofilm drugs abrogates dual species cariogenic biofilm formation in vitro. J. Oral Microbiol. 2022, 14, 1997230. [Google Scholar] [CrossRef]
- Yadav, K.; Prakash, S. Dental caries: A microbiological approach. J. Clin. Infect. Dis. Pract. 2017, 2, 1–15. [Google Scholar] [CrossRef]
- Colak, H.; Dulgergil, C.T.; Dalli, M.; Hamidi, M.M. Early childhood caries update: A review of causes, diagnoses, and treatments. J. Nat. Sci. Biol. Med. 2013, 4, 29–38. [Google Scholar] [CrossRef] [PubMed]
- Petersson, H.G.; Ericson, E.; Twetman, S. Preventive care delivered within Public Dental Service after caries risk assessment of young adults. Int. J. Dent. Hyg. 2016, 14, 215–219. [Google Scholar] [CrossRef] [PubMed]
- Pine, C.; Harris, V.R.; Burnside, G.; Merrett, M.C.E. An investigation of the relationship between untreated decayed teeth and sepsis in 5- year-old children. Br. Dent. J. 2006, 200, 45–47. [Google Scholar] [CrossRef] [PubMed]
- Sakaue, Y.; Takenaka, S.; Ohsumi, T.; Domon, H.; Terao, Y.; Noiri, Y. The effect of chlorhexidine on dental calculus formation: An in vitro study. BMC Oral Health 2018, 18, 52. [Google Scholar] [CrossRef]
- Chouhan, S.; Sharma, K.; Guleria, S. Antimicrobial activity of some essential oils-present status and future perspectives. Medicines 2017, 4, 58. [Google Scholar] [CrossRef]
- Gupta, A.; Mumtaz, S.; Li, C.H.; Hussain, I.; Rotello, V.M. Combatting Antibiotic-Resistant Bacteria using Nanomaterials. Chem. Soc. Rev. 2019, 48, 415–427. [Google Scholar] [CrossRef]
- Hisbiyah, A.; Fadhilah, L.N.; Hidayah, R. Antibacterial Activity of Sugarcane Bagasse Nanocellulose Biocomposite with Chitosan Against Escherichia coli. J. Kim. Val. 2021, 7, 28–37. [Google Scholar] [CrossRef]
- Coma, V.; Freire, V.; Silvestre, A. Recent Advances on the Development of Antibacterial Polysaccharide-Based Materials; Springer: Cham, Switzerland, 2015; pp. 1751–1803. [Google Scholar]
- Liu, Z.; Yan, J.; Miao, Y.-E.; Huang, Y.; Liu, T. Catalytic and antibacterial activities of greensynthesized silver nanoparticles on electrospun polystyrene nanofiber membranes using tea polyphenols. Compos. B Eng. 2015, 79, 17–23. [Google Scholar] [CrossRef]
- Ivask, A.; ElBadawy, A.; Kaweeteerawat, C.; Boren, D.; Fischer, H.; Ji, Z.; Chang, C.H.; Liu, R.; Tolaymat, T.; Telesca, D.; et al. Toxicity mechanisms in Escherichia coli vary for silver nanoparticles and differ from ionic silver. ACS Nano 2014, 8, 374. [Google Scholar] [CrossRef] [PubMed]
- Díez-Pascual, A.M.; Luceño-Sánchez, J.A. Antibacterial Activity of Polymer Nanocomposites Incorporating Graphene and Its Derivatives: A State of Art. Polymers 2021, 13, 2105. [Google Scholar] [CrossRef] [PubMed]
- Babayevska, N.; Przysiecka, L.; Iatsunskyi, I.; Nowaczyk, G.; Jarek, M.; Janiszewska, E.; Jurga, S. ZnO size and shape effect on antibacterial activity and cytotoxicity profile. Sci. Rep. 2022, 12, 8148. [Google Scholar] [CrossRef] [PubMed]
- Dong, Y.Y.; Liu, S.; Liu, Y.J.; Meng, L.Y.; Ma, M.G. Ag@ Fe3O4@ cellulose nanocrystals nanocomposites: Microwave-assisted hydrothermal synthesis, antimicrobial properties, and good adsorption of dye solution. J. Mater. Sci. 2017, 52, 8219–8230. [Google Scholar] [CrossRef]
- Saravanan, H.; Subramani, T.; Rajaramon, S.; David, H.; Sajeevan, A.; Sujith, S.; Solomon, A.P. Exploring nanocomposites for controlling infectious microorganisms: Charting the path forward in antimicrobial strategies. Front. Pharmacol. 2023, 14, 1282073. [Google Scholar] [CrossRef] [PubMed]
- Roy, A.; Bulut, O.; Some, S.; Mandal, A.K.; Yilmaz, M.D. Green synthesis of silver nanoparticles: Biomolecule-nanoparticle organizations targeting antimicrobial activity. RSC Adv. R. Soc. Chem. 2019, 9, 2673–2702. [Google Scholar] [CrossRef] [PubMed]
- Rajkumar, R.; Ezhumalai, G.; Gnanadesigan, M. A green approach for the synthesis of silver nanoparticles by Chlorella vulgaris and its application in photocatalytic dye degradation activity. Environ. Technol. Innov. 2021, 21, 101282. [Google Scholar] [CrossRef]
- Chugh, D.; Viswamalya, V.S.; Das, B. Green synthesis of silver nanoparticles with algae and the importance of capping agents in the process. J. Genet. Eng. Biotechnol. 2021, 19, 126. [Google Scholar] [CrossRef]
- Baghel, R.S.; Reddy, C.R.K.; Singh, R.P. Seaweed-based cellulose: Applications, and future perspectives. Carbohydr. Polym. 2021, 267, 118241. [Google Scholar] [CrossRef]
- Hamouda, R.A.; Qarabai, F.A.K.; Shahabuddin, F.S.; Al-Shaikh, T.M.; Rabab, R.M. Antibacterial Activity of Ulva/Nanocellulose and Ulva/Ag/Cellulose Nanocomposites and Both Blended with Fluoride against Bacteria Causing Dental Decay. Polymers 2023, 15, 1047. [Google Scholar] [CrossRef] [PubMed]
- Banas, J.A.; Takanami, E.; Hemsley, R.M.; Villhauer, A.; Zhu, M.; Qian, F.; Marolf, A.; Drake, D.R. Evaluating the relationship between acidogenicity and acid tolerance for oral streptococci from children with or without a history of caries. J. Oral Microbiol. 2020, 12, 1688449. [Google Scholar] [CrossRef] [PubMed]
- Takada, K.; Hayashi, K.; Sasaki, K.; Sato, T.; Hirasawa, M. Selectivity of Mitis Salivarius agar and a new selective medium for oral streptococci in dogs. J. Microbiol. Methods 2006, 66, 460–465. [Google Scholar] [CrossRef] [PubMed]
- Süle, J.; Kõrösi, T.; Hucker, A.; Varga, L. Evaluation of culture media for selective enumeration of bifidobacteria and lactic acid bacteria. Braz. J. Microbiol. 2014, 45, 1023–1030. [Google Scholar] [CrossRef] [PubMed]
- Hansen, D.S.; Jensen, A.; Norskov-Lauritsen, N.; Skov, R.; Bruun, B. Direct identification and susceptibility testing of enteric bacilli from positive blood cultures using VITEK (GNI/GNS-GA). Clin. Microbiol. Infect. 2002, 8, 38–44. [Google Scholar] [CrossRef]
- Spanu, T.; Sanguinetti, M.; Ciccaglione, D.; D’Inzeo, T.; Romano, L.; Leone, F.; Fadda, G. Use of the VITEK 2 System for Rapid Identification of Clinical Isolates of Staphylococci from Bloodstream Infections. J. Clin. Microbiol. 2003, 41, 4259–4263. [Google Scholar] [CrossRef]
- King, A.; Brown, D.F.J. Quality assurance of antimicrobial susceptibility testing by disc diffusion. J. Antimicrob. Chemother. 2001, 48, 71–76. [Google Scholar] [CrossRef]
- CLSI (Clinical & Laboratory Standards Institute). Performance Standard for Antimicrobial Susceptibility Testing. Available online: https://clsi.org/standards/products/microbiology/documents/m100/ (accessed on 12 November 2023).
- M02-A11; Performance Standards for Antimicrobial Disk Susceptibility Tests, Approved Standard. Clinical and Laboratory Standards Institute: Wayne, PA, USA, 2012.
- Stone, N.; Kendall, C.; Smith, J.; Crow, P.; Barr, H. Raman spectroscopy for identification of epithelial cancers. Faraday Discuss. 2004, 126, 141–157. [Google Scholar] [CrossRef]
- Danaei, M.; Dehghankhold, M.; Ataei, S.; Hasanzadeh Davarani, F.; Javanmard, R.; Dokhani, A.; Khorasani, S.; Mozafari, M.R. Impact of particle size and polydispersity index on the clinical applications of lipidic nanocarrier systems. Pharmaceutics 2018, 10, 57. [Google Scholar] [CrossRef]
- Hamouda, R.A.; Abd El Maksoud, A.I.; Wageed, M.; Alotaibi, A.S.; Elebeedy, D.; Khalil, H.; Abdella, A. Characterization and anticancer activity of biosynthesized Au/cellulose nanocomposite from Chlorella vulgaris. Polymers 2021, 13, 3340. [Google Scholar] [CrossRef]
- Madhiyazhagan, P.; Murugan, K.; Kumar, A.N.; Nataraj, T.; Subramaniam, J.; Chandramohan, B.; Panneerselvam, C.; Dinesh, D.; Suresh, U.; Nicoletti, M. One pot synthesis of silver nanocrystals using the seaweed Gracilaria edulis: Biophysical characterization and potential against the filariasis vector Culex quinquefasciatus and the midge Chironomus circumdatus. J. Appl. Phycol. 2017, 29, 649–659. [Google Scholar] [CrossRef]
- Nandiyanto, A.B.; Oktiani, R.; Ragadhita, R. How to read and interpret FTIR spectroscope of organic material. Indones. J. Sci. Technol. 2019, 4, 97–118. [Google Scholar] [CrossRef]
- Annamalai, J.; Nallamuthu, T. Characterization of biosynthesized gold nanoparticles from aqueous extract of Chlorella vulgaris and their anti-pathogenic properties. Appl. Nanosci. 2015, 5, 603–607. [Google Scholar] [CrossRef]
- Liu, Y.; Wang, H.; Yu, G.; Yu, Q.; Li, B.; Mu, X. A novel approach for the preparation of nanocrystalline cellulose by using phosphotungstic acid, Carbohydr. Polymers 2014, 110, 415–422. [Google Scholar] [CrossRef]
- Rahman, M.S.; Rana, M.; Spitzhorn, L.-S.; Akhtar, N.; Hasan, M.Z.; Choudhury, N.; Fehm, T.; Czernuszka, J.T.; Adjaye, J.; Asaduzzaman, S.M. Fabrication of biocompatible porous scaffolds based on hydroxyapatite/collagen/chitosan composite for restoration of defected maxillofacial mandible bone. Prog. Biomater. 2019, 8, 137–154. [Google Scholar] [CrossRef]
- Bahmid, N.A.; Syamsu, K.; Maddu, A. Production of Cellulose Acetate from Oil Palm Empty Fruit Bunches Cellulose. Chem. Process Eng. Res. 2013, 17, 12–20. [Google Scholar]
- Fung, M.F.K.; Senterman, M.K.; Mikhael, N.Z.; Lacelle, S.; Wong, P.T. Pressure-tuning Fourier transform infrared spectroscopic study of carcinogenesis in human endometrium. Biospectroscopy 1996, 2, 155–165. [Google Scholar] [CrossRef]
- Sasi, S.; Krishna, C.A.; Sugunan, S.K.; Chandran, A.; Nair, P.R.; Subramanian, K.R.V.; Mathew, S. Low cost, high efficiency flexible supercapacitor electrodes made from areca nut husk nanocellulose and silver nanoparticle embedded polyaniline. RSC Adv. 2021, 11, 29564–29575. [Google Scholar] [CrossRef]
- Fan, L.; Zhang, H.; Gao, M.; Zhang, M.; Liu, P.; Liu, X. Cellulose nanocrystals/silver nanoparticles: In situ preparation and application in PVA films. Holzforschung 2020, 74, 523–528. [Google Scholar] [CrossRef]
- Muthulakshmi, L.; Rajini, N.; Rajalu, A.V.; Siengchin, S.; Kathiresan, T. Synthesis and characterization of cellulose/silver nanocomposites from bioflocculant reducing agent. Int. J. Biol. Macromol. 2017, 103, 1113–1120. [Google Scholar] [CrossRef]
- Raghavendraa, G.M.; Jayaramudu, T.; Varaprasad, K.; Sadiku, R.; Ray, S.; Raju, K.M. Cellulose–polymer–Ag nanocomposite fibers for antibacterial fabrics/skin scaffolds. Carbohydr. Polym. 2013, 93, 553–560. [Google Scholar] [CrossRef] [PubMed]
- Tan, Z.; Chen, S.; Peng, X.; Zhang, L.; Gao, C. Polyamide membranes with nanoscale Turing structures for water purification. Science 2018, 360, 518–521. [Google Scholar] [CrossRef] [PubMed]
- Joudeh, N.; Linke, D. Nanoparticle classifcation, physicochemical properties, characterization, and applications: A comprehensive review for biologists. J. Nanobiotechnology 2022, 20, 262. [Google Scholar] [CrossRef] [PubMed]
- Hamouda, R.A.; Hussein, M.H.; Elhadary, A.M.A.; Abuelmagd, M.A. Extruded polysaccharide/protein matrix from Arthrospira platensis cultures mediated silver nanoparticles biosynthesis and capping. Appl. Nanosci. 2020, 10, 3839–3855. [Google Scholar] [CrossRef]
- Huang, R.; Li, M.; Gregory, R.L. Bacterial interactions in dental biofilm. Virulence 2011, 2, 435–444. [Google Scholar] [CrossRef] [PubMed]
- Dinis, M.; Agnello, M.; Cen, L.; Shokeen, B.; He, X.; Shi, W.; Wong, D.T.W.; Tran, N.C. Oral Microbiome: Streptococcus mutans/Caries Concordant-Discordant Children. Front. Microbiol. 2022, 13, 782825. [Google Scholar] [CrossRef] [PubMed]
- Krzyściak, W.; Jurczak, A.; Kościelniak, D.; Bystrowska, B.; Skalniak, A. The virulence of Streptococcus mutans and the ability to form biofilms. Eur. J. Clin. Microbiol. Infect. Dis. 2014, 33, 499–515. [Google Scholar] [CrossRef]
- Lemos, J.A.; Burne, R.A. A model of efficiency: Stress tolerance by Streptococcus mutans. Microbiology 2008, 154, 3247–3255. [Google Scholar] [CrossRef]
- Alash, S.A.; Mohammed, M.Q. Antibacterial activity of some mouthwash solutions against Staphylococcus lentus isolated from mouth infections. Iraqi J. Sci. 2019, 60, 2583–2589. [Google Scholar] [CrossRef]
- Eick, S.; Ramseier, C.A.; Rothenberger, K.; Brägger, U.; Buser, D.; Salvi, G.E. Microbiota at teeth and implants in partially edentulous patients. A 10-year retrospective study. Clin. Oral Implant. Res. 2016, 27, 218–225. [Google Scholar] [CrossRef]
- Wen, Z.T.; Huang, X.; Ellepola, K.; Liao, S.; Li, Y. Lactobacilli and human dental caries: More than mechanical retention. Microbiology 2022, 168, 001196. [Google Scholar] [CrossRef] [PubMed]
- Schoilewa, K.; Ueffing, H.; Dalpke, A.; Wolff, B.; Frese, C. Bacterial biofilm composition in healthy subjects with and without caries experience. J. Oral Microbiol. 2019, 11, 1633194. [Google Scholar] [CrossRef]
- Serwecińska, L. Antimicrobials and Antibiotic-Resistant Bacteria: A Risk to the Environment and to Public Health. Water 2020, 12, 3313. [Google Scholar] [CrossRef]
- Nguyen, B.T.; Chen, Q.L.; He, J.Z.; Hu, H.W. Microbial regulation of natural antibiotic resistance: Understanding the protist-bacteria interactions for evolution of soil resistome. Sci. Total Environ. 2020, 705, 13588. [Google Scholar] [CrossRef]
- Duin, D.V.; Paterson, D. Multidrug Resistant Bacteria in the Community: Trends and Lessons Learned. Infect. Dis. Clin. N. Am. 2016, 30, 377–390. [Google Scholar] [CrossRef] [PubMed]
- Kapoor, G.; Saigal, S.; Elongavan, A. Action and resistance mechanisms of antibiotics: A guide for clinicians. J. Anesthesiol. Clin. Pharmacol. 2017, 33, 300–305. [Google Scholar] [CrossRef] [PubMed]
- Cao, Y.; Naseri, M.; He, Y.; Xu, C.; Walsh, L.J.; Ziora, Z.M. Nonantibiotic antimicrobial agents to combat biofilm-forming bacteria. J. Glob. Antimicrob. Resist. 2020, 21, 445–451. [Google Scholar] [CrossRef] [PubMed]
- Bush, K.; Bradford, P.A. β-Lactams and β-Lactamase Inhibitors: An Overview. Cold Spring Harb. Perspect. Med. 2016, 6, a025247. [Google Scholar] [CrossRef] [PubMed]
- Peterson, E.; Kaur, P. Antibiotic Resistance Mechanisms in Bacteria: Relationships between Resistance Determinants of Antibiotic Producers, Environmental Bacteria, and Clinical Pathogens. Front. Microbiol. 2018, 9, 2928. [Google Scholar] [CrossRef]
- Krakovka, S.; Ribacke, U.; Miyamoto, Y.; Eckmann, L.; Svärd, S. Characterization of Metronidazole-Resistant Giardia intestinalis Lines by Comparative Transcriptomics and Proteomics. Front. Microbiol. 2022, 13, 834008. [Google Scholar] [CrossRef]
- Reygaert, W.C. An overview of the antimicrobial resistance mechanisms of bacteria. AIMS Microbiol. 2018, 4, 482–501. [Google Scholar] [CrossRef] [PubMed]
- Abou Neel, E.A.; Aljabo, A.; Strange, A.; Ibrahim, S.; Coathup, M. Demineralization–remineralization dynamics in teeth and bone. Int. J. Nanomed. 2016, 11, 4743–4763. [Google Scholar] [CrossRef] [PubMed]
- Mitwalli, H.; Balhaddad, A.A.; AlSahafi, R.; Oates, T.W.; Melo, M.A.S.; Xu, H.H.K.; Weir, M.D. Novel CaF2 Nanocomposites with Antibacterial Function and Fluoride and Calcium Ion Release to Inhibit Oral Biofilm and Protect Teeth. J. Funct. Biomater. 2020, 11, 56. [Google Scholar] [CrossRef] [PubMed]
- Akram, F.E.; El-Tayeb, T.; Abou-Aisha, K.; El-Azizi, M. A combination of silver nanoparticles and visible blue light enhances the antibacterial efficacy of ineffective antibiotics against methicillin-resistant Staphylococcus aureus (MRSA). Ann. Clin. Microbiol Antimicrob. 2016, 15, 48. [Google Scholar] [CrossRef] [PubMed]
- Liao, S.; Zhang, Y.; Pan, P.; Zhu, F.; Jiang, C.; Liu, Q.; Cheng, Z.; Dai, G.; Wu, G.; Wang, L.; et al. Antibacterial activity and mechanism of silver nanoparticles against multidrug-resistant Pseudomonas aeruginosa. Int. J. Nanomed. 2019, 14, 1469–1487. [Google Scholar] [CrossRef] [PubMed]
- Wang, L.; Hu, C.; Shao, L. The antimicrobial activity of nanoparticles: Present situation and prospects for the future. Int. J. Nanomed. 2017, 12, 1227–1249. [Google Scholar] [CrossRef] [PubMed]
- Qing, Y.; Cheng, L.; Li, R.; Liu, G.; Zhang, Y.; Tang, X.; Wang, J.; Liu, H.; Qin, Y. Potential antibacterial mechanism of silver nanoparticles and the optimization of orthopedic implants by advanced modification technologies. Int. J. Nanomed. 2018, 13, 3311–3327. [Google Scholar] [CrossRef]
- More, P.R.; Pandit, S.; De Filippis, A.; Franci, G. Silver Nanoparticles: Bactericidal and Mechanistic Approach against Drug Resistant Pathogens. Microorganisms 2023, 11, 369. [Google Scholar] [CrossRef]
- Errokh, A.; Magnin, A.; Putaux, J.L.; Boufi, S. Hybrid nanocellulose decorated with silver nanoparticles as reinforcing filler with antibacterial properties. Mater. Sci. Eng. 2019, 105, 110044. [Google Scholar] [CrossRef]
- Ramarajua, B.; Imaea, T.; Destaye, A.G. Ag nanoparticle-immobilized cellulose nanofibril films for environmental conservation. Appl. Catal. A Gen. 2015, 492, 184–189. [Google Scholar] [CrossRef]
- Kim, J.; Kwon, S.; Ostler, E. Antimicrobial effect of silver-impregnated cellulose: Potential for antimicrobial therapy. J. Biol. Eng. 2009, 3, 20. [Google Scholar] [CrossRef] [PubMed]

| 2 Theta | Sin Theta | hkl | D (nm) | Intensity % |
|---|---|---|---|---|
| 11.5169 | 0.100334799 | 100 | 40.16 | 5.58 |
| 20.6775 | 0.17946759 | 111 | 33.08 | 10.51 |
| 23.2611 | 0.2016002 | 200 | 12.35 | 3.15 |
| 27.7198 | 0.239548602 | 211 | 26.12 | 45.55 |
| 28.9014 | 0.249546871 | 211 | 35.53 | 6.15 |
| 29.5627 | 0.25513104 | 211 | 65.04 | 0.95 |
| 30.9599 | 0.266901148 | 211 | 29.93 | 10.64 |
| 31.6265 | 0.272502759 | 220 | 38.83 | 32.05 |
| 32.1345 | 0.276765431 | 220 | 27.70 | 100 |
| 36.2324 | 0.310945169 | 310 | 42.63 | 2.42 |
| 37.2304 | 0.319210732 | 310 | 38.25 | 2.83 |
| 43.3728 | 0.369526204 | 321 | 20.84 | 1.3 |
| 45.4086 | 0.385975277 | 321 | 24.82 | 20.18 |
| 47.5831 | 0.403410353 | 400 | 15.39 | 1 |
| 49.0656 | 0.415214098 | 410 | 61.19 | 0.87 |
| 54.6861 | 0.4593171 | 421 | 21.08 | 14.53 |
| 55.8432 | 0.468262953 | 421 | 35.66 | 1.01 |
| 56.497 | 0.473296605 | 421 | 22.22 | 4.54 |
| 57.3153 | 0.479575026 | 422 | 23.61 | 13.84 |
| 58.2132 | 0.486436029 | 430 | 44.09 | 0.6 |
| 66.0993 | 0.545365585 | 521 | 37.59 | 1.66 |
| 67.3334 | 0.554360806 | 521 | 27.54 | 5.48 |
| Test | Strepto thoraltensis | Strepto alactolyticus | Strepto mutans | Strepto salivarius | Strepto sanguinis | Staph lentus | Staph hominis | Granulicatella adiacens | Gemella sanguinis | Kytococcus | Kocuria kristinae | Aerococcus viridans | Leuconosticme senteroides |
|---|---|---|---|---|---|---|---|---|---|---|---|---|---|
| D-amygdalin | + | + | + | + | + | + | − | − | − | − | − | + | − |
| Ala-Phe-Pro arylamidase | + | + | − | + | − | − | − | − | − | − | − | − | − |
| Leucine arylamidase | + | + | − | + | + | − | − | + | − | − | − | − | − |
| Alanine arylamidase | + | + | + | + | + | − | − | − | − | + | − | − | − |
| D-ribose | − | − | − | − | − | − | − | − | − | − | − | − | − |
| Novobiocin resistance | − | + | − | + | − | − | + | + | − | − | − | − | − |
| Pullulan | + | + | − | − | − | + | − | − | − | − | − | − | − |
| Bacitracin resistance | + | + | − | + | − | − | + | + | − | − | − | − | − |
| Alpha-glucosidase | − | − | − | + | − | − | + | − | − | − | − | − | − |
| D-galactose | + | + | + | + | + | + | − | − | − | − | + | + | − |
| Beta-glucuronidase | − | − | − | − | − | − | − | − | − | − | − | − | − |
| Phosphatase | − | − | − | − | − | − | + | − | − | − | − | − | − |
| Arginine dihydrolase 2 | − | − | − | − | − | − | − | − | − | − | − | − | |
| D-trehalose | + | + | + | − | + | − | + | − | + | − | − | − | − |
| Alpha-mannosidase | − | − | − | − | − | − | − | − | − | − | − | − | − |
| Saccharose/sucrose | + | + | + | + | + | + | + | + | − | − | + | + | + |
| L-lactate alkalinization | − | − | − | − | − | − | + | − | − | − | − | − | − |
| beta-glucuronidase | − | − | − | − | − | − | − | − | − | − | − | − | − |
| N-acetyl-d-glucosamine | + | + | − | + | + | + | + | − | − | − | − | − | − |
| Urease | − | − | − | + | + | − | + | − | − | − | − | − | − |
| D-sorbitol | + | + | - | − | − | + | − | − | − | − | − | − | − |
| Salicin | + | − | + | + | + | + | − | − | − | − | + | + | + |
| arginine dihydrolase 1 | − | − | − | − | − | − | + | + | − | − | − | − | − |
| D-xylose | + | + | − | − | − | + | − | − | − | − | − | + | − |
| phosphatidylinositol phospholipase c | − | − | − | − | − | − | − | − | − | − | − | − | − |
| Growth in 6.5% Nacl | − | − | − | − | − | − | + | − | − | − | − | − | − |
| Novobiocin resistance | − | + | − | + | − | − | + | + | − | − | − | − | − |
| Test | Lactobacillus acidophilus | Lactobacillus plantarum | Corynebacterium Group f-1 |
|---|---|---|---|
| Ala-Phe-Pro arylamidase | + | − | − |
| Beta-galactosidase | + | − | − |
| Alpha-mannosidase | − | − | − |
| Beta-glucuronidase | − | − | − |
| D-galactose | + | + | + |
| L-lactate alkalinization | − | − | − |
| D-Ribose | − | + | + |
| D-sorbitol | − | + | − |
| D-trehalose | + | + | − |
| D-xylose | − | − | − |
| D-sorbitol | − | + | − |
| D-galactose | + | + | + |
| Beta-glucuronidase | − | − | − |
| Alpha-mannosidase | − | − | − |
| Saccharose/sucrose | + | + | + |
| Urease | + | − | + |
| Ellman | − | − | − |
| Succinate alkalinization | − | − | − |
| Phosphatase | − | − | + |
| Alpha Glucosidase | − | − | + |
| Arginine dihydrolase 2 | − | − | − |
| Pullulan | + | + | − |
| Bacitracin Resistance | + | − | + |
| D-Maltose | + | + | + |
| Strain | Strain Code | Zone of Inhibition (mm) | |||||
|---|---|---|---|---|---|---|---|
| PG (10 µg) | AUG (30 µg) | MZ (5 µg) | AP (10 µg) | CIP (5 µg) | TS (25 µg) | ||
| Streptococcus thoraltensi | 27 | 30 (S) | 30 (S) | 0 (R) | 30 (S) | 30 (S) | 30 (S) |
| 20 | 30 (S) | 33 (S) | 0 (R) | 30 (S) | 30 (S) | 25 (S) | |
| Streptococcus alactolyticus | 58 | 19 (S) | 28 (S) | 0 (R) | 23 (S) | 24 (S) | 14 (I) |
| 48 | 15 (S) | 30 (S) | 0 (R) | 24 (S) | 21 (S) | 25 (S) | |
| Streptococcus mutans | 8 | 16 (S) | 30 (S) | 0 (R) | 23 (S) | 26 (S) | 13 (I) |
| 11 | 22 (S) | 33 (S) | 0 (R) | 30 (S) | 40 (S) | 0 (R) | |
| Streptococcus salivarius | 12 | 0 (R) | 0 (R) | 0 (R) | 0 (R) | 0 (R) | 0 (R) |
| 14 | 0 (R) | 0 (R) | 0 (R) | 0 (R) | 0 (R) | 0 (R) | |
| Streptococcus sanguinis | 47 | 12 (R) | 19 (S) | 0 (R) | 17 (S) | 30 (S) | 20 (S) |
| 30 | 13 (R) | 28 (S) | 0 (R) | 30 (S) | 28 (S) | 15 (S) | |
| 38 | 14 (R) | 35 (S) | 0 (R) | 28 (S) | 28 (S) | 27 (S) | |
| Staphylococcus lentus | 63 | 18 (S) | 28 (S) | 0 (R) | 17 (S) | 25 (S) | 25 (S) |
| 56 | 17 (S) | 30 (S) | 0 (R) | 28 (S) | 25 (S) | 27 (S) | |
| 54 | 24 (S) | 35 (S) | 0 (R) | 35 (S) | 25 (S) | 25 (S) | |
| 49 | 20 (S) | 30 (S) | 0 (R) | 25 (S) | 27 (S) | 30 (S) | |
| 32 | 20 (S) | 30 (S) | 0 (R) | 30 (S) | 30 (S) | 30 (S) | |
| 28 | 15 (S) | 30 (S) | 0 (R) | 32 (S) | 27 (S) | 25 (S) | |
| Staphylococcus hominis spp. | 36 | 18 (S) | 23 (S) | 0 (R) | 22 (S) | 36 (S) | 22 (S) |
| Granulicatella adiacens | 40 | 20 (S) | 30 (S) | 0 (R) | 30 (S) | 30 (S) | 30 (S) |
| 43 | 15 (S) | 35 (S) | 0 (R) | 33 (S) | 30 (S) | 30 (S) | |
| Granulicatella elegans | 25 | 30 (S) | 30 (S) | 0 (R) | 30 (S) | 22 (S) | 30 (S) |
| Gemella morbillorum | 60 | 25 (S) | 30 (S) | 0 (R) | 35 (S) | 24 (S) | 25 (S) |
| Gemella sanguinis | 65 | 20 (S) | 30 (S) | 0 (R) | 30 (S) | 18 (I) | 20 (S) |
| 51 | 15 (S) | 28 (S) | 0 (R) | 28 (S) | 25 (S) | 29 (S) | |
| Kytococcus | 52 | 0 (R) | 0 (R) | 0 (R) | 0 (R) | 0 (R) | 0 (R) |
| Kocuria kristinae | 10 | 0 (R) | 25 (S) | 0 (R) | 0 (R) | 0 (R) | 0 (R) |
| 62 | 0 (R) | 20 (S) | 0 (R) | 0 (R) | 0 (R) | 0 (R) | |
| 39 | 12 (R) | 30 (S) | 0 (R) | 0 (R) | 0 (R) | 0 (R) | |
| 55 | 13(R) | 30(S) | 0(R) | 0(R) | 0(R) | 0 (R) | |
| Aerococcus viridans | 50 | 20 (S) | 32 (S) | 0 (R) | 30 (S) | 21 (S) | 25 (S) |
| Leuconostoc mesenteroides ssp cremoris | 61 | 20 (S) | 30 (S) | 0 (R) | 30 (S) | 25 (S) | 22 (S) |
| Lactobacillus acidophilus | 19 | 25 (S) | 30 (S) | 0 (R) | 30 (S) | 30 (S) | 30 (S) |
| 64 | 20 (S) | 20 (S) | 0 (R) | 28 (S) | 26 (S) | 32 (S) | |
| 29 | 25 (S) | 30 (S) | 0 (R) | 30 (S) | 25 (S) | 25 (S) | |
| 31 | 15 (S) | 26 (S) | 0 (R) | 25 (S) | 25 (S) | 22 (S) | |
| 33 | 16 (S) | 27 (S) | 0 (R) | 23 (S) | 25 (S) | 20 (S) | |
| 34 | 15 (S) | 25 (S) | 0 (R) | 25 (S) | 25 (S) | 20 (S) | |
| 35 | 17 (S) | 20 (S) | 0 (R) | 19 (S) | 25 (S) | 25 (S) | |
| 37 | 15 (S) | 24 (S) | 0 (R) | 24 (S) | 25 (S) | 24 (S) | |
| 42 | 25 (S) | 30 (S) | 0 (R) | 25 (S) | 25 (S) | 25 (S) | |
| 45 | 23 (S) | 35 (S) | 0 (R) | 26 (S) | 25 (S) | 25 (S) | |
| 46 | 21 (S) | 30 (S) | 0 (R) | 28 (S) | 23 (S) | 26 (S) | |
| 5 | 20 (S) | 35 (S) | 0 (R) | 17 (S) | 25 (S) | 25 (S) | |
| 53 | 17 (S) | 33 (S) | 0 (R) | 23 (S) | 23 (S) | 25 (S) | |
| 57 | 19 (S) | 30 (S) | 0 (R) | 25 (S) | 20 (I) | 22 (S) | |
| 59 | 16 (S) | 30 (S) | 0 (R) | 27 (S) | 22 (S) | 23 (S) | |
| Lactobacillus plantarum | 9 | 0 (R) | 35 (S) | 0 (R) | 30 (S) | 0 (R) | 30 (S) |
| Corynebacterium group f-1 | 22 | 15 (S) | 22 (S) | 0 (R) | 22 (S) | 25 (S) | 21 (S) |
| Resistant percentage % | 23% | 7% | 100% | 17% | 21% | 21% | |
| Strain | Patient Number | Cellulose | F | NC | Cellulose/F | NC/F | AgNPs | AgNPs/F | Ag/NC | Ag/NC/F |
|---|---|---|---|---|---|---|---|---|---|---|
| Streptococcus thoraltensi | 27 | nd | nd | nd | nd | 15 ± 0.28 | 22 ± 0.17 | 19 ± 0.11 | 20 ± 0.57 | 20 ± 0.57 |
| 20 | nd | nd | nd | 10 ± 0.2 | 20 ± 0.0 | 20 ± 0.0 | 20 ± 0.23 | 21 ± 0.3 | 20 ± 1.15 | |
| Streptococcus alactolyticus | 58 | nd | nd | nd | nd | nd | 20 ± 0.72 | 20 ± 0 | 22 ± 0 | 23 ± 0.57 |
| 48 | nd | nd | nd | 17 ± 0.57 | 20 ± 0.0 | 20 ± 0.0 | 13 ± 0 | 20 ± 0.72 | 20 ± 0 | |
| Streptococcus mutans | 8 | nd | nd | nd | 23 ± 0.28 | 22 ± 0.17 | 20 ± 0.72 | 22 ± 0.4 | 24 ± 0.28 | 26 ± 1 |
| 11 | nd | nd | nd | nd | 20 ± 0.35 | 20 ± 0.11 | 21 ± 0.15 | 18 ± 0.41 | 20 ± 0.57 | |
| Streptococcus salivarius | 12 | nd | nd | nd | nd | 16 ± 0.28 | 19 ± 0.0 | 15 ± 0.28 | 20 ± 041 | 22 ± 0.57 |
| 14 | nd | nd | nd | nd | 15 ± 0.23 | 18 ± 0.25 | 19 ± 0.0 | 14 ± 0.28 | 20 ± 1.15 | |
| Streptococcus sanguinis | 47 | nd | nd | nd | nd | 22 ± 0.57 | 20 ± 0.25 | 21 ± 0.0 | 22 ± 0.17 | 25 ± 0.57 |
| 30 | nd | nd | nd | nd | 13 ± 0.4 | 20 ± 0.0 | 22 ± 0.11 | 22 ± 0.2 | 21 ± 0 | |
| 38 | nd | nd | nd | nd | 22 ± 0.28 | 20 ± 0.0 | 22 ± 0.17 | 20 ± 0.4 | 23 ± 0.57 | |
| Staphylococcus lentus | 63 | nd | nd | nd | nd | 16 ± 0.0 | 22 ± 0.41 | 21 ± 0.45 | 23 ± 0.23 | 23 ± 1 |
| 56 | nd | nd | nd | nd | nd | 21 ± 0.05 | 22 ± 0.57 | 20 ± 0.5 | 20 ± 0.7 | |
| 54 | nd | nd | nd | nd | nd | 20 ± 0.23 | 21 ± 0.57 | 20 ± 0 | 22 ± 1.15 | |
| 49 | nd | nd | nd | nd | nd | 20 ± 0.36 | 23 ± 0.17 | 23 ± 0 | 25 ± 1.15 | |
| 32 | nd | nd | nd | 10 ± 0.0 | 21 ± 0.28 | 20 ± 0.35 | 22 ± 0.28 | 19 ± 0.23 | 20 ± 0.57 | |
| 28 | nd | nd | nd | nd | 20 ± 0.2 | 18 ± 0.75 | 20 ± 0.25 | 22 ± 0 | 21 ± 0.14 | |
| Granulicatella adiacens | 36 | nd | nd | nd | nd | nd | 23 ± 0.0 | 22 ± 0.48 | 22 ± 0.28 | 25 ± 1.17 |
| Granulicatella elegans | 40 | nd | nd | nd | 25 ± 0.28 | 27 ± 0.57 | 23 ± 0.57 | 25 ± 0.46 | 25 ± 0.1 | 22 ± 0.3 |
| 43 | nd | nd | nd | nd | 29 ± 0.0 | 20 ± 0.28 | 19 ± 0.17 | 25 ± 0 | 27 ± 0.57 | |
| Gemella morbillorum | 25 | nd | nd | nd | 19 ± 0.17 | nd | 23 ± 0.23 | 24 ± 0.11 | 20 ± 0.11 | 21 ± 0.8 |
| Gemella morbillorum | 60 | nd | nd | nd | nd | nd | 21 ± 0.0 | 22 ± 0.41 | 26 ± 0.23 | 24 ± 0.13 |
| Gemella sanguinis | 65 | nd | nd | nd | nd | nd | 2.0 ± 0.57 | 20 ± 0.57 | 21 ± 0.4 | 20 ± 0.57 |
| 51 | nd | nd | nd | nd | 10 ± 0.28 | 22 ± 0.57 | 15 ± 0.42 | 20 ± 0 | 20 ± 1.15 | |
| Kytococcus | 52 | nd | nd | nd | nd | nd | 20 ± 0.46 | 19 ± 0.2 | 21 ± 0 | 23 ± 1.7 |
| Kocuria kristinae | 10 | nd | nd | nd | 20 ± 0.14 | 20 ± 0.17 | 15 ± 0.57 | 18 ± 0.25 | 21 ± 0.28 | 21 ± 0.57 |
| 62 | nd | nd | nd | nd | nd | 20 ± 0.36 | 21 ± 0.057 | 23 ± 00.17 | 25 ± 0.57 | |
| 39 | nd | nd | nd | nd | nd | 20 ± 0.23 | 2.1 ± 0.23 | 20 ± 0.57 | 20 ± 1.15 | |
| 55 | nd | nd | nd | nd | nd | 14 ± 0.28 | 13 ± 0.57 | 14 ± 0.26 | 10 ± 0 | |
| Aerococcus viridans | 50 | nd | nd | nd | nd | nd | 22 ± 0.41 | 22 ± 0.41 | 12 ± 0.2 | 20 ± 0.28 |
| Leuconostoc mesenteroides | 61 | nd | nd | nd | nd | nd | 20 ± 0.20 | 20 ± 0.72 | 20 ± 0.23 | 22 ± 0.28 |
| Lactobacillus acidophilus | 19 | nd | nd | nd | nd | nd | 20 ± 0.11 | 22 ± 0.0 | 20 ± 0.36 | 22 ± 0.23 |
| 64 | nd | nd | nd | 0 | 0 | 19 ± 0.2 | 18 ± 0.0 | 20 ± 0 | 20 ± 0.11 | |
| 29 | nd | nd | nd | 0 | 0 | 20 ± 0.0 | 20 ± 0.2 | 20 ± 0 | 25 ± 0.46 | |
| 31 | nd | nd | nd | nd | nd | 20 ± 0.69 | 20 ± 0.35 | 20 ± 0.45 | 12 ± 0.46 | |
| 33 | nd | nd | nd | nd | nd | 25 ± 0.23 | 23 ± 0.47 | 12 ± 0.0 | 22 ± 0.46 | |
| 34 | nd | nd | nd | nd | nd | 20 ± 0.51 | 20 ± 0.57 | 20 ± 0.34 | 19 ± 0.4 | |
| 35 | nd | nd | nd | nd | nd | 20 ± 0.0 | 20 ± 0.41 | 20 ± 0.57 | 17 ± 0.3 | |
| 37 | nd | nd | nd | nd | nd | 20 ± 0.57 | 20 ± 0.40 | 20 ± 0.2 | 18 ± 0.25 | |
| 42 | nd | nd | nd | nd | nd | 2.0 ± 0.41 | 19 ± 0.0 | 22 ± 0.0 | 25 ± 0.57 | |
| 45 | nd | nd | nd | nd | nd | 12 ± 0.0 | 22 ± 0.4 | 25 ± 0.2 | 27 ± 0.4 | |
| 46 | nd | nd | nd | nd | nd | 24 ± 0.28 | 21 ± 0.11 | 22 ± 0.0 | 23 ± 0.34 | |
| 5 | nd | nd | nd | nd | nd | 20 ± 0.60 | 20 ± 0.28 | 22 ± 0.11 | 23 ± 0.28 | |
| 53 | nd | nd | nd | nd | nd | 23 ± 0.28 | 23 ± 0.58 | 25 ± 0.11 | 25 ± 0.28 | |
| 57 | nd | nd | nd | nd | nd | 20 ± 0.52 | 21 ± 0 | 22 ± 0 | 14 ± 0.82 | |
| 59 | nd | nd | nd | nd | nd | 22 ± 0.0 | 22 ± 0.28 | 20 ± 0 | 25 ± 0.28 | |
| Lactobacillus plantarum | 9 | nd | nd | nd | nd | nd | 20 ± 0.0 | 17 ± 0.58 | 20 ± 0.23 | 21 ± 0.23 |
| Corynebacterium group f-1 | 22 | nd | nd | nd | nd | nd | 20 ± 0.57 | 18 ± 0.25 | 20 ± 0.23 | 19 ± 0.57 |
Disclaimer/Publisher’s Note: The statements, opinions and data contained in all publications are solely those of the individual author(s) and contributor(s) and not of MDPI and/or the editor(s). MDPI and/or the editor(s) disclaim responsibility for any injury to people or property resulting from any ideas, methods, instructions or products referred to in the content. |
© 2023 by the authors. Licensee MDPI, Basel, Switzerland. This article is an open access article distributed under the terms and conditions of the Creative Commons Attribution (CC BY) license (https://creativecommons.org/licenses/by/4.0/).
Share and Cite
Hamouda, R.A.; Makharita, R.R.; Qarabai, F.A.K.; Shahabuddin, F.S.; Saddiq, A.A.; Bahammam, L.A.; El-Far, S.W.; Bukhari, M.A.; Elaidarous, M.A.; Abdella, A. Antibacterial Activities of Ag/Cellulose Nanocomposites Derived from Marine Environment Algae against Bacterial Tooth Decay. Microorganisms 2024, 12, 1. https://doi.org/10.3390/microorganisms12010001
Hamouda RA, Makharita RR, Qarabai FAK, Shahabuddin FS, Saddiq AA, Bahammam LA, El-Far SW, Bukhari MA, Elaidarous MA, Abdella A. Antibacterial Activities of Ag/Cellulose Nanocomposites Derived from Marine Environment Algae against Bacterial Tooth Decay. Microorganisms. 2024; 12(1):1. https://doi.org/10.3390/microorganisms12010001
Chicago/Turabian StyleHamouda, Ragaa A., Rabab R. Makharita, Fauzia A. K. Qarabai, Fathi S. Shahabuddin, Amna A. Saddiq, Laila Ahmed Bahammam, Shaymaa W. El-Far, Mamdouh A. Bukhari, Mohammad A. Elaidarous, and Asmaa Abdella. 2024. "Antibacterial Activities of Ag/Cellulose Nanocomposites Derived from Marine Environment Algae against Bacterial Tooth Decay" Microorganisms 12, no. 1: 1. https://doi.org/10.3390/microorganisms12010001
APA StyleHamouda, R. A., Makharita, R. R., Qarabai, F. A. K., Shahabuddin, F. S., Saddiq, A. A., Bahammam, L. A., El-Far, S. W., Bukhari, M. A., Elaidarous, M. A., & Abdella, A. (2024). Antibacterial Activities of Ag/Cellulose Nanocomposites Derived from Marine Environment Algae against Bacterial Tooth Decay. Microorganisms, 12(1), 1. https://doi.org/10.3390/microorganisms12010001






